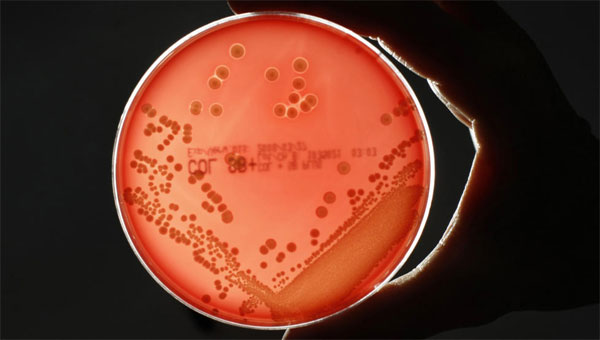

Tổ chức Y tế Thế giới (WHO) cảnh báo tình trạng thuốc kháng sinh mất hiệu lực trước nhiều "siêu vi khuẩn" đang gia tăng trên toàn cầu. Nhưng mới đây, các nhà khoa học Anh vui mừng thông báo họ đã phát hiện một điểm yếu trong hệ thống phòng thủ của "siêu vi khuẩn", có thể nâng cao hiệu quả điều trị các bệnh nhiễm trùng không đáp ứng với thuốc kháng sinh.
Tổ chức Y tế Thế giới (WHO) cảnh báo tình trạng thuốc kháng sinh mất hiệu lực trước nhiều “siêu vi khuẩn” đang gia tăng trên toàn cầu. Nhưng mới đây, các nhà khoa học Anh vui mừng thông báo họ đã phát hiện một điểm yếu trong hệ thống phòng thủ của “siêu vi khuẩn”, có thể nâng cao hiệu quả điều trị các bệnh nhiễm trùng không đáp ứng với thuốc kháng sinh.
Công bố trên tạp chí Nature, nhóm nghiên cứu thuộc Trường Y Norwich của Đại học Đông Anglia cho biết đã xác định được nhân tố ảnh hưởng đến vách tế bào vốn đóng vai trò là “hàng rào bảo vệ” của hầu hết các vi khuẩn kháng thuốc. Cụ thể, Giáo sư Changjiang Dong cùng cộng sự đã tìm ra cách thức và con đường vận chuyển những phân tử cấu thành nên lớp màng ngăn chặn tác nhân bên ngoài xâm nhập tế bào vi khuẩn gram âm. Quan trọng hơn hết, nhóm chuyên gia đã chứng minh được vi khuẩn sẽ chết nếu “cánh cửa” này bị vô hiệu hóa.
![]() |
Theo Giáo sư Dong, phát hiện trên rất quan trọng bởi vi khuẩn kháng thuốc đang trở thành vấn nạn toàn cầu khiến hàng trăm nghìn người chết mỗi năm. Trong đó, tụ cầu khuẩn vàng kháng trụ sinh (khuẩn MRSA) đặc biệt nguy hiểm vì chúng có khả năng kháng nhiều loại thuốc kháng sinh.
Do vậy, các chuyên gia tin tưởng phát hiện này có thể giúp điều chế nhiều loại thuốc mới tấn công trực tiếp vào thành tế bào vi khuẩn chứ không cần xâm nhập vào trong để tiêu diệt chúng, qua đó ngăn vi khuẩn phát triển khả năng kháng thuốc.
Theo khoahoc





